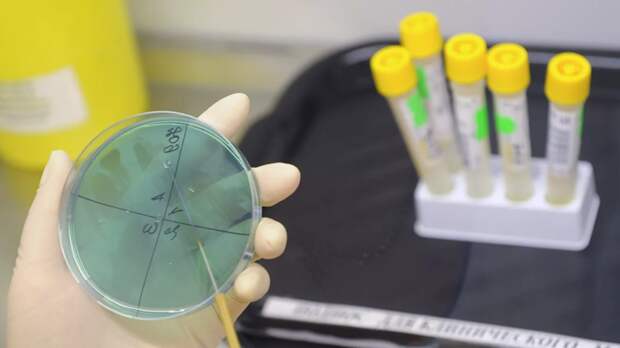

Группа медицинских экспертов из Китая, прилетевших в Россию для помощи в борьбе с коронавирусом, посетила три больницы в Москве.
Об этом информирует РИА Новости со ссылкой на члена делегации, руководителя Центра по контролю и профилактике заболеваний провинции Хэйлунцзян Вана Кайли.
«(Группа экспертов. — RT) работает по установленному московскими властями порядку, мы уже посетили три медицинских учреждения, а также провели обсуждение и обмен мнениями с российскими специалистами», — сказал он.
Кайли добавил, что специалисты из КНР посетили больницу в Коммунарке, ГКБ №15 имени О.М. Филатова и строящийся инфекционный центр в поселении Вороновское.
По его словам, в ближайшие дни эксперты могут посетить ещё несколько учреждений.
Ранее Китай направил в Россию медиков для помощи в борьбе с коронавирусом.
Свежие комментарии